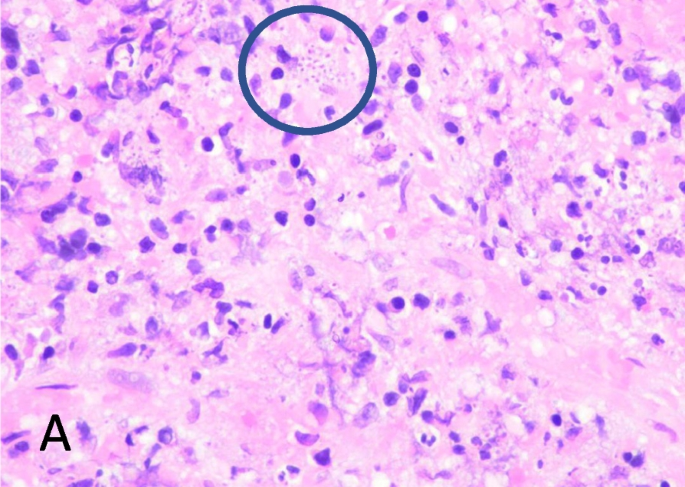

- Case Report
- Open access
- Published:
Primary laryngeal histoplasmosis: a case report
The Egyptian Journal of Otolaryngology volume 39, Article number: 155 (2023)
Abstract
Background
Histoplasmosis is a fungal infection that commonly occurs in the lungs or in disseminated form. Primary laryngeal histoplasmosis is a very rare condition that can mimic laryngeal carcinoma or laryngeal tuberculosis. The purpose of this case report is to highlight the rare occurrence of primary laryngeal histoplasmosis with no involvement of other organs, especially the lungs, the diagnosis dilemma, and the antifungal protocol for this case.
Case presentation
We report a case of a 47-year-old male, who is a pigeon breeder, presented with chronic hoarseness. There were no signs of pulmonary or systemic involvement. Biopsy from laryngeal mucosa was confirmed as histoplasmosis, and he was started on intravenous (IV) amphotericin B for 2 weeks and oral itraconazole for 2 months.
Conclusion
Primary laryngeal histoplasmosis is considered a very rare occurrence. The laryngeal lesion may mimic conditions such as laryngeal carcinoma and laryngeal tuberculosis. Histopathology examination remains the gold standard, and antifungal treatment is the choice of therapy.
Background
Primary laryngeal histoplasmosis, an infection by the intracellular fungus Histoplasma capsulatum (H. capsulatum), is a very rare occurrence [1]. It is highly associated with the involvement of other organs, and the organism is usually disseminated from the pulmonary system [2]. Its features greatly mimic laryngeal tuberculosis or laryngeal cancer, which poses a challenge to many clinicians in diagnosing this condition [2]. Histoplasmosis usually spreads through inhalation of fungal spores and generally occurs in immunocompromised patients [3]. The purpose of this case report is to highlight the rare occurrence of primary laryngeal histoplasmosis with no involvement of other organs, especially the lungs, the diagnosis dilemma, and the antifungal protocol for this case.
Case presentation
A 47-year-old Malay gentleman presented with a history of hoarseness for 5 months. He also complains of dysphagia, odynophagia, intermittent fever, and a chronic dry cough for the same duration. He has had significant weight loss (almost 20 kg) in the last 5 months and a loss of appetite. He has no dyspnea or noisy breathing, and he has had no tuberculosis contact.
Further history-taking revealed that the patient was newly diagnosed with diabetes mellitus, but he is not compliant on his medications. The patient has been an active smoker for the past 30 years, and he has prolonged exposure to bird droppings because he breeds pigeons.
Clinically, he has no respiratory distress, and there was no stridor. However, the patient’s voice appears to be hoarse. A neck examination showed a palpable lymph node over the right level II region, measuring 1 × 1 cm, firm, non-tender, mobile, and well-bordered. Flexible nasopharyngolaryngoscopy showed that the bilateral arytenoids were edematous, and there was an ulcerative lesion over the laryngeal surface of the epiglottis, bilateral arytenoids, and bilateral false cords. Screening for HIV, hepatitis B and C, and tuberculosis was negative. Computed tomography (CT) of the neck, thorax, and pelvis was performed, and they showed an enlarged cervical lymph node at right cervical level II, an enhanced and mildly irregular laryngeal wall, bilateral lung cavities with centrilobular nodules, and a hypodense area within the spleen, which may represent a local infarct.
Direct laryngoscopy under general anaesthesia revealed an irregular exophytic lesion over the lingual and laryngeal surfaces of the epiglottis, bilateral false cords, and bilateral arytenoids. The examination of the subglottic region and trachea was normal. A biopsy was taken of the exophytic lesions (Figs. 1, 2, 3, 4, 5 and 6).
Histopathological examination showed fragments of inflamed fibrocollagenous tissue covered by focally ulcerated stratified squamous epithelium. The inflammatory cells consist of mainly lymphocytes and epithelioid histiocytes, as well as some Langerhans giant cells. No caseous necrotic areas are seen. There is no malignancy. Budding yeasts are identified with Grocott’s methenamine silver and periodic acid-Schiff stains, and histoplasmosis was isolated from culture.
The patient was started on intravenous (IV) amphotericin B at 0.5 mg/kg/day for 2 weeks and continued with oral itraconazole 200 mg three times daily for 2 months on the advice of an infectious disease specialist. During follow-up, the patient’s clinical symptoms had resolved, and repeated flexible nasopharyngolaryngoscopy showed the laryngeal lesions were resolving.
Discussion
Laryngeal histoplasmosis is a disease caused by a dimorphic fungus, Histoplasma capsulatum. It usually favours growth in acidic soil with a high nitrogen content, usually derived from avian excreta and bat guano [1]. Histoplasmosis was first described by a pathologist, Samuel Taylor Darling, in 1906. The organism was first isolated during the autopsy of a patient, and it was subsequently made post-mortem until the year 1934 [1]. Dodd and Tompkins managed to diagnose histoplasmosis in a living infant in 1934 [1].
Histoplasmosis is a disease caused by inhaling the spores of H. capsulatum. In general, it cannot be transmitted from human to human. The method of transmission is initiated by inhaling the spores of H. capsulatum in the form of microconidia. The fungus exists in a mycelial phase at room temperature. Once it reaches the lung parenchyma, it is converted to yeast due to the increased body temperature of the human body [4]. Subsequently, it will be phagocytosed by macrophages in the lung parenchyma [3].
The structure of the organism expresses heat shock protein 60 (HSP60), which binds to 2 integrins on the surface of macrophages. Next, the histoplasma stimulates the macrophages to secrete tumour necrosis factor, which will also lead to further recruitment of other macrophages. Inside the macrophages, the fungus will germinate, giving rise to blastopores. Hence, in immunocompetent patients, there is inflammation at the site of infection. The subsequent fate of the fungus depends on the immune system of the patient. The fungus is usually destroyed, and the infection is resolved, or the patient will be asymptomatic. On the contrary, in immune-deficient patients, the fungus is released from the phagolysosome, where it will multiply freely and spread to other organs of the body [4, 5].
Histoplasmosis is categorised into four main clinical variants. They are acute pulmonary, acute disseminated, chronic disseminated, and chronic pulmonary [6]. Acute pulmonary histoplasmosis is the most frequently seen variant. Disseminated variants are rare and usually seen in immunocompromised patients, children less than 2 years old, and the elderly [1]. Laryngeal histoplasmosis occurs in the chronic disseminated variant, and in this form, pulmonary symptoms are less obvious, and there is more involvement of the mucous membranes and skin, for instance, oropharyngeal ulcerations [6]. A systematic review on laryngeal histoplasmosis concluded that the prevalence of laryngeal involvement in chronic pulmonary histoplasmosis was 66%, 31% in acute pulmonary histoplasmosis, and only 19% in acute disseminated histoplasmosis [7]. In the same study, risk factors mentioned are immunocompromised states (AIDS, diabetes mellitus, patients on immunosuppressant drugs), history of travelling to endemic areas, smokers, history of tuberculosis, and patients with endocrinology diseases [7]. In another separate article, individuals who worked as construction workers, bridge inspectors, painters, farmers, and cave explorers were more likely to be infected by H. capsulatum [3]. The patient reported in our case report has a hobby of keeping pigeons, which puts him highly vulnerable.
Multiple studies have reported that laryngeal histoplasmosis manifests symptoms such as hoarseness, dysphagia, odynophagia, sore throat, dyspnea, lethargy, and weight loss [3, 6, 8]. Features that can be observed in a direct laryngoscopy include a pearl-white appearance, granulomas, nodular ulcerative lesions, verrucous lesions, and plaque-like lesions on the laryngeal mucosa [3, 6, 8, 9]. The commonest reported sites in the larynx were false cords and aryepiglottic folds [8]. Based on clinical findings, a set of differential diagnoses needs to be considered, such as carcinoma, tuberculosis, lymphoma, syphilis, papillomatosis, amyloidosis, and sarcoidosis [1, 2]. In our case, the patient complained of hoarseness but had no dyspnea or noisy breathing considering the severity of the lesion. This can be explained because the bulk of the lesion only involved the supraglottic structures, and the glottic region was clear of any lesion. The significance of weight loss in our patient is that it may influence a diagnosis of laryngeal malignancy. Nonetheless, the cause of the weight loss in our patient is due to his dysphagia, which affects his oral intake.
A biopsy or swab should be performed on the laryngeal lesions for culture or histopathological examination to ascertain the diagnosis. To confirm the diagnosis of histoplasmosis, there are special staining methods, such as hematoxylin and eosin, Grocott’s methenamine silver, and periodic acid-Schiff stains [3, 6]. In the staining, hyphae can be seen in macrophages, and granulomas can also be seen [10]. The fungus can be successfully isolated on Sabouraud’s agar; however, this procedure may take up to 6 weeks [6]. Microscopically, histoplasmosis may have tuberculoid granulomas with caseous necrosis areas, which are features of tuberculosis, and chronic fungal infection may induce pseudoepitheliomatous hyperplasia, which mimics squamous cell carcinoma [3, 10]. Chest radiography, bone marrow biopsies, sputum, and urine cultures are recommended in laryngeal histoplasmosis cases to rule out disseminated disease [7]. In regards to the clinical signs on the laryngeal mucosa and histopathological examination, it poses a diagnosis dilemma as laryngeal carcinoma or laryngeal tuberculosis may also have similar appearances. Thus, it should be stressed that a thorough history-taking and physical examination should not only focus on the head and neck region. This is due to the fact that laryngeal histoplasmosis is usually associated with disseminated disease, with the digestive air tract and lungs specifically mentioned in various literatures [5].
The mainstay of treatment is IV amphotericin B, which is very effective for disseminated disease, and itraconazole to be given in the follow-up period. According to the Infectious Diseases Society of America, the recommended dosage for amphotericin B is 0.7–1.0 mg/kg/day, with a 2–4-month total administered dose of 35 mg/kg, and the dosage for itraconazole is 200 mg daily [3, 6]. Oral fluconazole (200–400 mg once a day) or oral ketoconazole (200–400 mg once daily) is alternatives if patients cannot tolerate amphotericin B, as studies have shown that oral antifungal’s effectiveness is comparable to amphotericin B [6, 11].
Conclusion
Primary laryngeal histoplasmosis is rare, as it is usually associated with disseminated disease that involves mainly the lungs. As a matter of fact, histoplasmosis should come to mind when diagnosing laryngeal pathology, especially in patients who have potential exposure or are immunocompromised. Due to the fact that its clinical features are not specific, it can lead to misdiagnosis, which may explain the low number of reported cases. The otolaryngologist should be aware of the existence of this condition and consider it a differential diagnosis in cases of laryngeal mass. Subsequently, perform specific staining to identify the organism and initiate the recommended antifungal treatment.
Availability of data and materials
Authors can confirm that all relevant data are included in the article.
Abbreviations
- CT:
-
Computed tomography
- IV:
-
Intravenous
References
Chakravarti A, Nair RR, Mojahid M et al (2001) Pharyngo-laryngeal histoplasmosis in an immunocompromised child—a case report. Egypt J Otolaryngol 37:84
Moriones Robayo CA, Guerra Ortiz CP (2014) Histoplasmosis laryngeal: report first case in Colombia. Colomb Med (Cali) 45(4):186–189
Teoh JW, Hassan F, Mohamad Yunus MR (2013) Laryngeal histoplasmosis: an occupational hazard. Singapore Med J 54(10):208–210
Subramaniam S, Abdullah AH, Hairuzah I (2005) Histoplasmosis of the larynx. Med J Malaysia 60(3):386–388
Ansari HA, Saeed N, Khan N, Hasan N (2016) Laryngeal histoplasmosis. BMJ Case Reports. bcr2016216423. https://doi.org/10.1136/bcr-2016-216423
Bist S, Sandhir S, Shirazi N, Agarwal V, Bharti B (2015) Primary histoplasmosis of larynx mimicking as laryngeal carcinoma. Int J Phonosurg Laryngol 5:28–31
Ramadan O (2016) Laryngeal histoplamosis overview. Otolaryngol Open J 2(5):141–149
Sonkhya N, Mehta R, Sonkhya D, Gupta S, Faujdar M (2013) Primary histoplasmosis of larynx: a case series and review of literature. Int J Otolaryngol Head Neck Surg 2(2):47–51
Habib SK, Patwary SA, Imran Khan MA, Miah MT, Gupta RD, Ahasan HN (2012) Primary histoplasmosis of vocal cord in an immunocompetent elderly man- a case report with literature review. J Med 13(1):77–81
Sobrinho FP, Negra MD, Queiroz W, Ribeiro UJ, Bittencourt S, Klautau GB (2007) Histoplasmosis of the larynx. Braz J Otorhinolaryngol 73(6):857–861
Wheat J, Sarosi G, McKinsey D et al (2000) Practice guidelines for the management of patients with histoplasmosis. Clin Infect Dis 30:688–95 Infectious Diseases Society of America
Acknowledgements
Not applicable.
Funding
Not applicable.
Author information
Authors and Affiliations
Contributions
YKF performed the flexible laryngoscopy and evaluated the clinical findings and contributed to the manuscript; SMY performed the direct laryngoscopy, evaluated the clinical findings, and contributed to the manuscript; and NFH evaluated the clinical findings and revised the manuscript. All authors have read and approved the final manuscript.
Corresponding authors
Ethics declarations
Ethics approval and consent to participate
Ethical approval was not required for this case report. Written informed consent for participation was obtained from the patient.
Consent for publication
Written informed consent for publication was obtained from the patient.
Competing interests
The authors declare that they have no competing interests.
Additional information
Publisher’s Note
Springer Nature remains neutral with regard to jurisdictional claims in published maps and institutional affiliations.
Rights and permissions
Open Access This article is licensed under a Creative Commons Attribution 4.0 International License, which permits use, sharing, adaptation, distribution and reproduction in any medium or format, as long as you give appropriate credit to the original author(s) and the source, provide a link to the Creative Commons licence, and indicate if changes were made. The images or other third party material in this article are included in the article's Creative Commons licence, unless indicated otherwise in a credit line to the material. If material is not included in the article's Creative Commons licence and your intended use is not permitted by statutory regulation or exceeds the permitted use, you will need to obtain permission directly from the copyright holder. To view a copy of this licence, visit http://creativecommons.org/licenses/by/4.0/.
About this article
Cite this article
Yuen, K.F., Soo, M.Y. & Nik Hassan, N.F.H. Primary laryngeal histoplasmosis: a case report. Egypt J Otolaryngol 39, 155 (2023). https://doi.org/10.1186/s43163-023-00519-8
Received:
Accepted:
Published:
DOI: https://doi.org/10.1186/s43163-023-00519-8